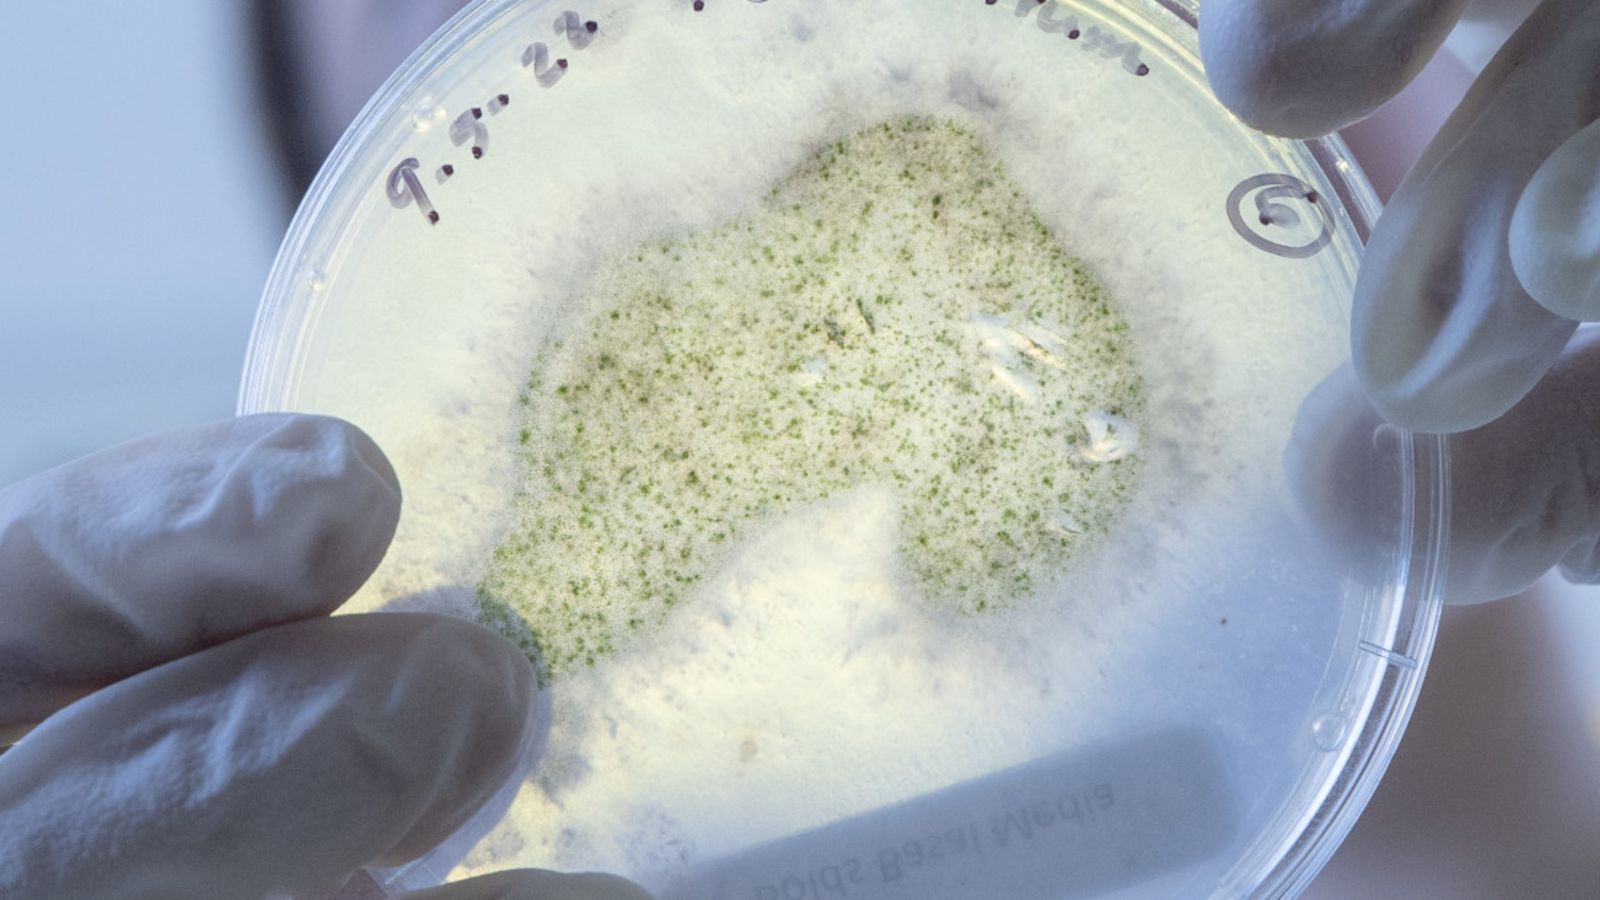

Undergraduate study
Find out about the undergraduate degrees that we offer at the Faculty of Science and Engineering.
Bachelor of Biomedical Science
Study at the cutting-edge of science, while gaining a new understanding of health issues and exploring cures for diseases.

Bachelor of Engineering with Honours
Study a four-year professional degree that’s accredited by Engineering New Zealand to internationally recognised benchmarks.

Bachelor of Environment and Society
Pursue your passion for environmental issues. Tackle the big questions and arm yourself with the knowledge to drive change.

Bachelor of Science
Follow your passion, develop problem-solving skills, and dive into a fascinating career with a Bachelor of Science.
Plan your study
Visit our site for future students to explore what you can study at Te Herenga Waka—Victoria University of Wellington whether you're starting your university studies, extending your degree, or looking to develop professionally.
If you have questions about what to study, book an appointment with one of our friendly team of advisers. They can talk you through all our qualification options and how our degrees work, create a course plan with you, and answer any questions you have about admission, enrolment, accommodation, and scholarships.
- Explore all of the University's qualifications, subjects and courses
- Book a study advice appointment
- Find out how an undergraduate degree works
Visit our site for future students
